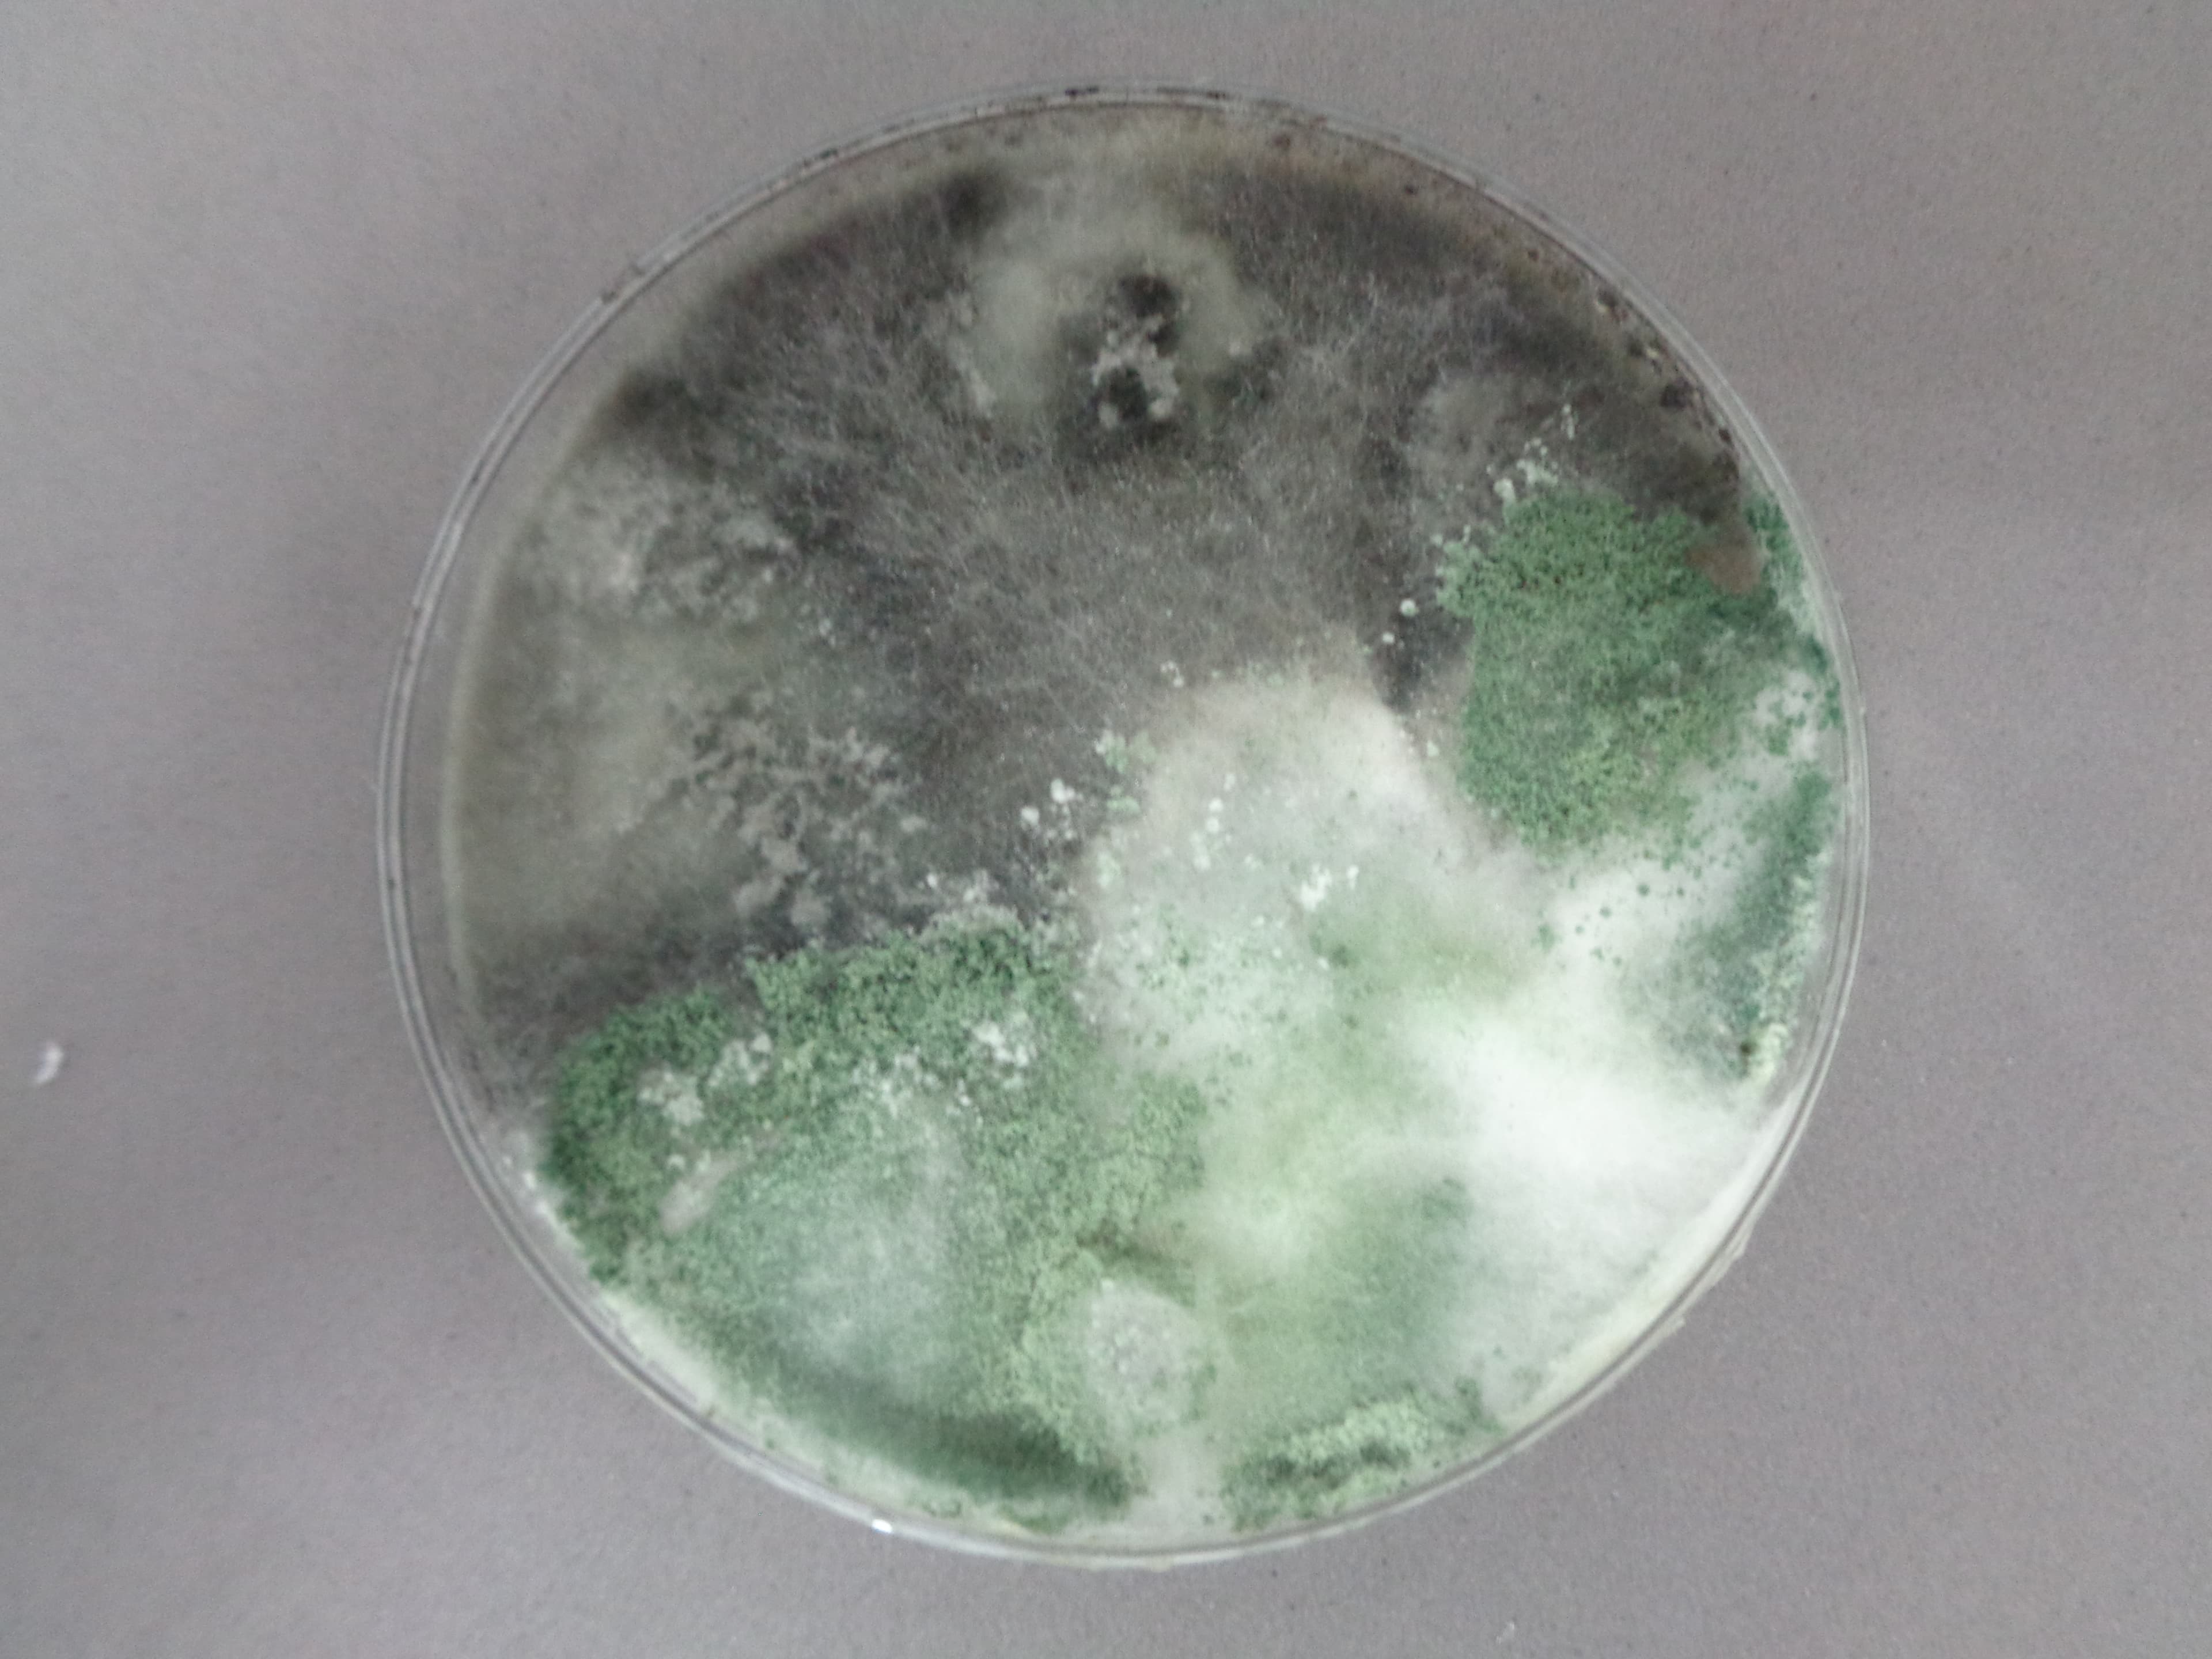
Trichoderma crecimiento
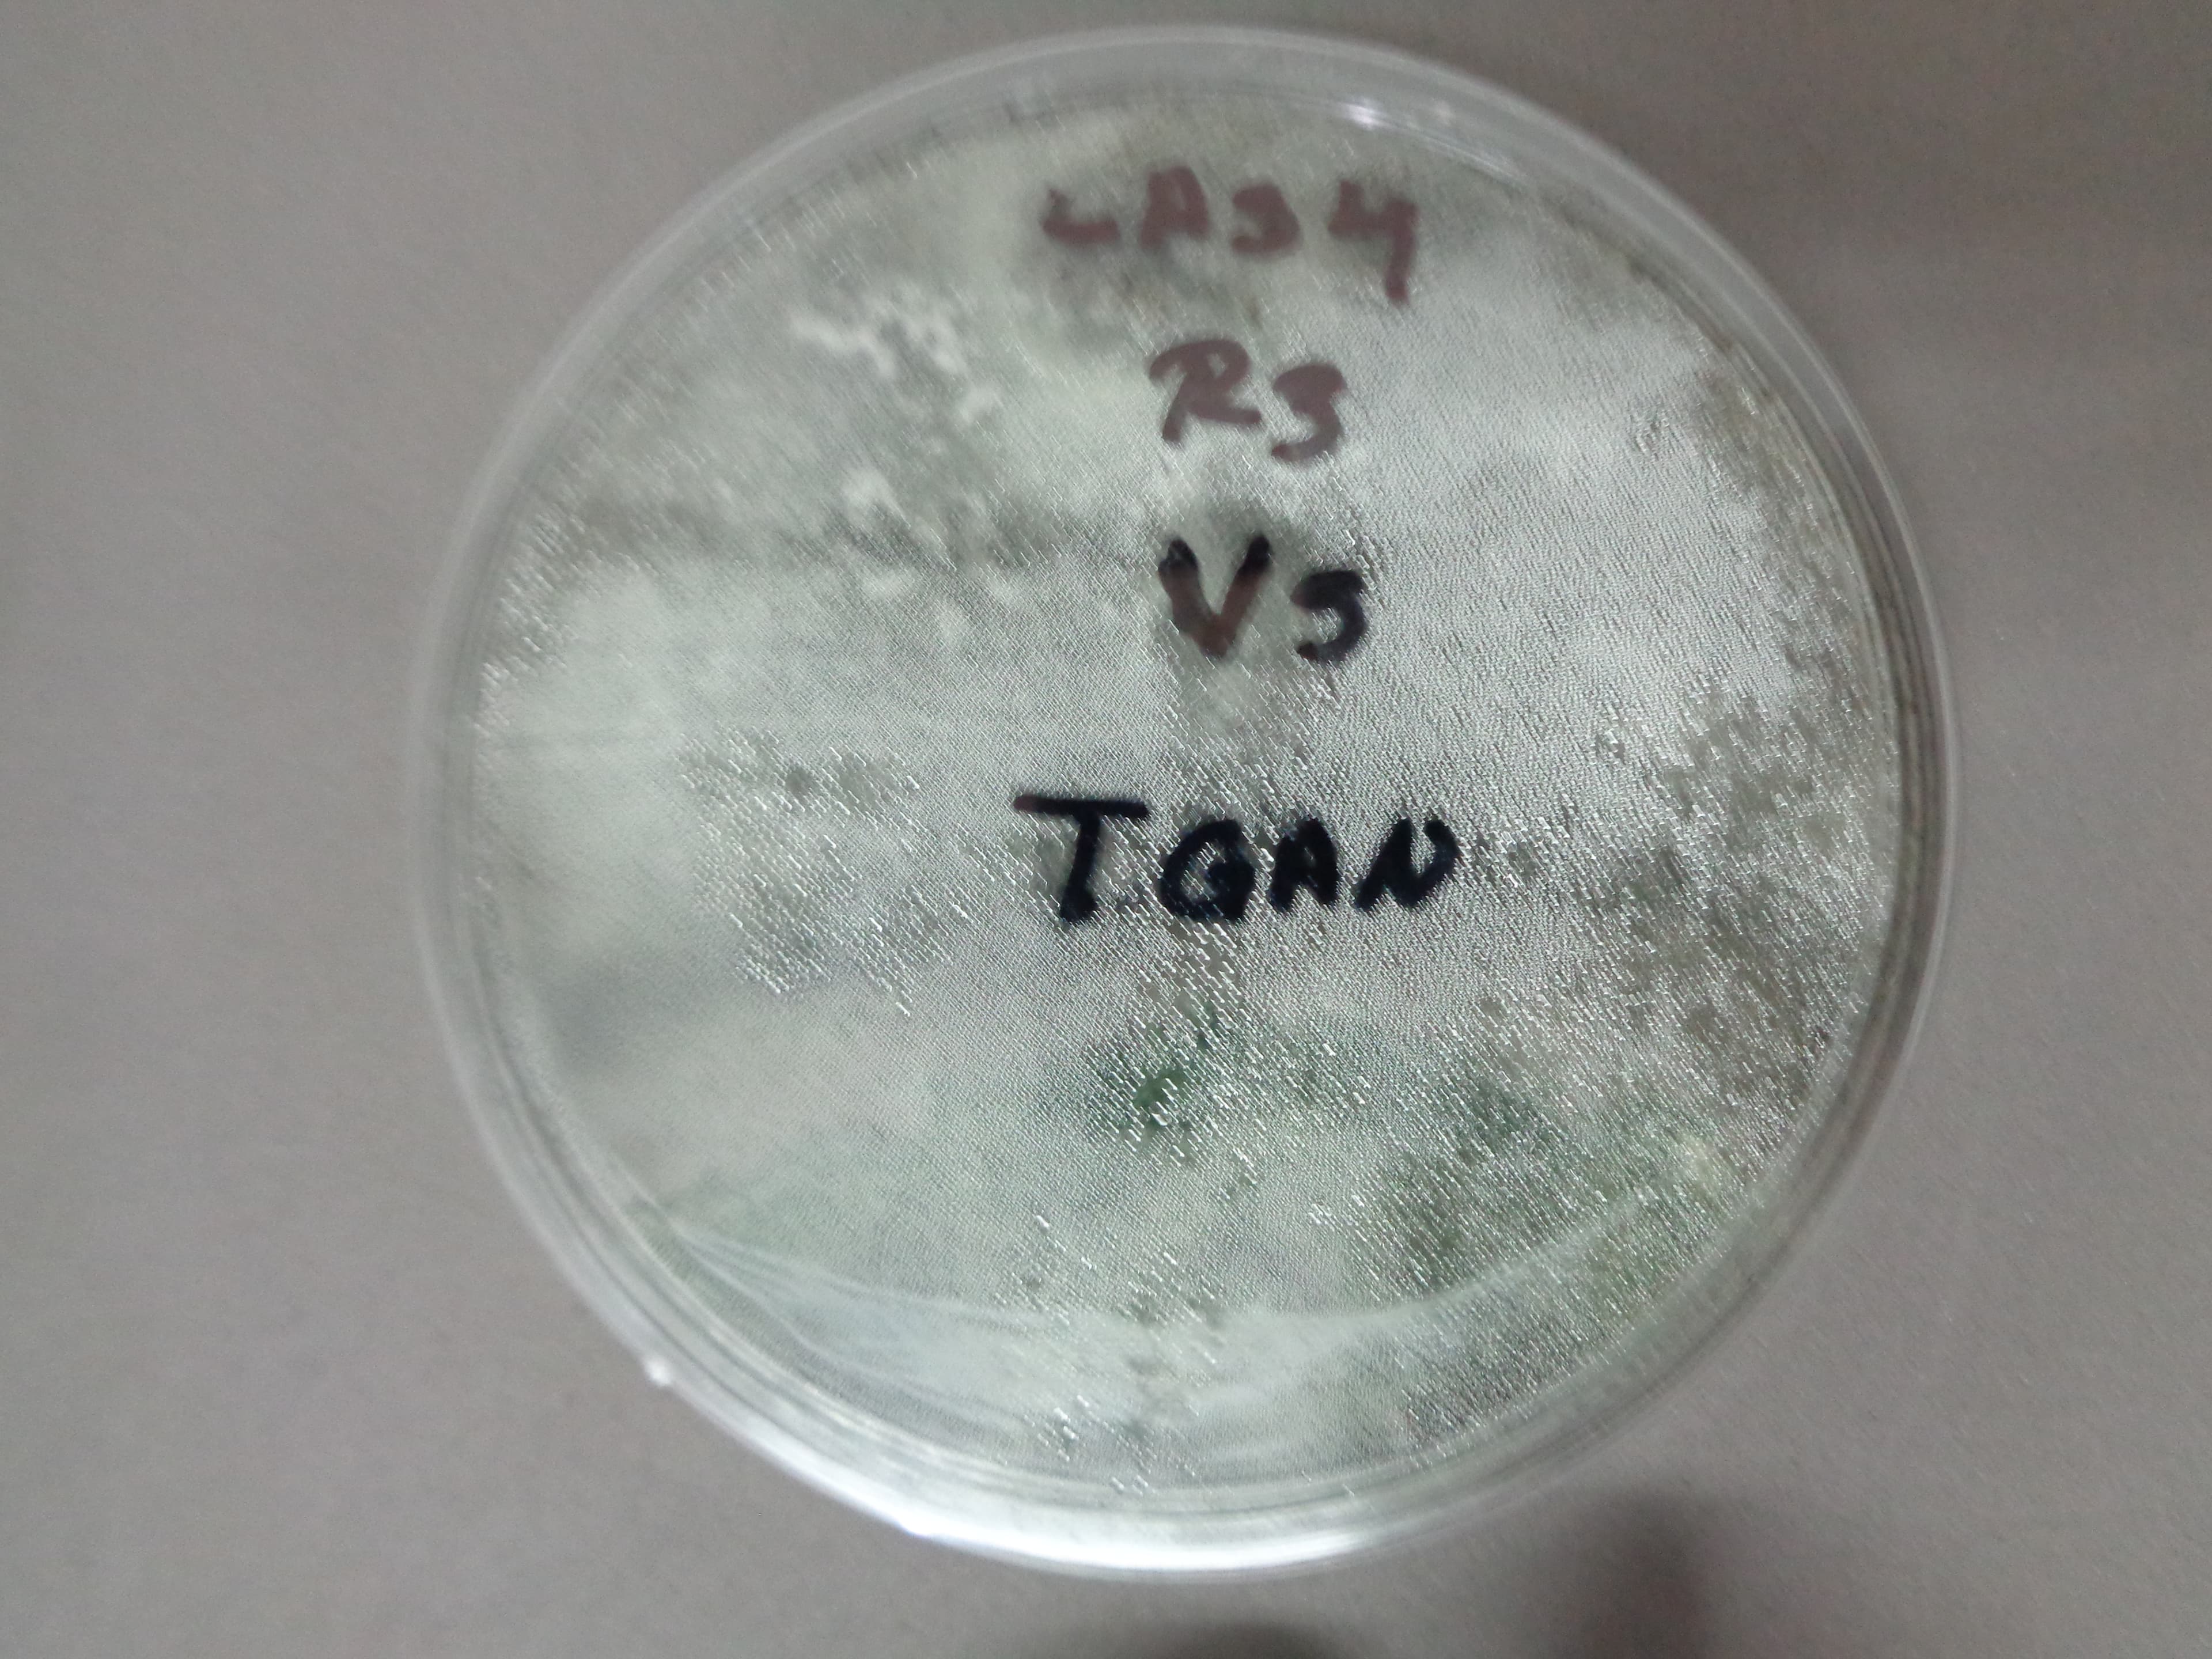
Trichoderma antagonismo

Actualizaciones y Descubrimientos
Articulos de divulgacion, hallazgos recientes y novedades en el campo de la micologia aplicada.

Microscopia de Colletotrichum spp.: El Agente Causal de la Antracnosis en Maracuya
Estudio fotografico detallado de las estructuras morfologicas del patogeno aislado de frutos de maracuya, mostrando conidias, apresorios y acervulos. Fotografia cientifica por Santo Angel OA.
Trichoderma spp.: El Aliado Natural Contra la Antracnosis
Revision de los mecanismos de accion de Trichoderma como agente de biocontrol, incluyendo micoparasitismo, antibiosis e induccion de resistencia sistemica en plantas de maracuya.
Todas las Publicaciones
Identificacion de Sintomas de Antracnosis en Follaje de Maracuya
Guia visual para el reconocimiento temprano de lesiones causadas por Colletotrichum en hojas, incluyendo patrones de manchas necroticas y halos cloroticos.
Antracnosis en Frutos de Maracuya: Perdidas en Poscosecha
Analisis del impacto economico de la antracnosis en frutos de maracuya durante la poscosecha y estrategias de manejo para reducir mermas.
Ensayos de Antagonismo In Vitro: Trichoderma vs Colletotrichum
Resultados de cultivos duales mostrando la capacidad antifungica de aislamientos nativos de Trichoderma contra Colletotrichum spp.
Protocolo de Aislamiento y Multiplicacion de Trichoderma spp.
Guia paso a paso para el aislamiento desde suelo, purificacion en medio selectivo y multiplicacion masiva del biocontrolador.
El Complejo de Especies Colletotrichum: Taxonomia Molecular
Como las herramientas moleculares (ITS, GAPDH, CHS) han revolucionado la clasificacion de este complejo generico.